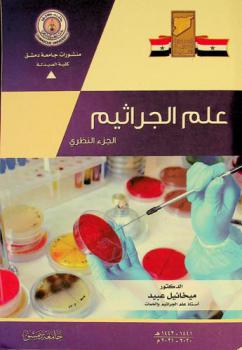
علم الجراثيم : الجزء النظري

Asset Details
MbrlCatalogueTitleDetail
Do you wish to reserve the book?

الجراثيم العلامة
by
Cole, Joanna. مؤلف
, Degen, Bruce رسام
, Cole, Joanna. The giant germ
in
الأحياء الدقيقة أدب الناشئة
/ الجراثيم أدب الناشئة
/ ثقافة الأطفال أدب الناشئة
2006

Hey, we have placed the reservation for you!
By the way, why not check out events that you can attend while you pick your title.
You are currently in the queue to collect this book. You will be notified once it is your turn to collect the book.

Oops! Something went wrong.
Looks like we were not able to place the reservation. Kindly try again later.
Are you sure you want to remove the book from the shelf?

Oops! Something went wrong.
While trying to remove the title from your shelf something went wrong :( Kindly try again later!
Do you wish to request the book?

الجراثيم العلامة
by
Cole, Joanna. مؤلف
, Degen, Bruce رسام
, Cole, Joanna. The giant germ
in
الأحياء الدقيقة أدب الناشئة
/ الجراثيم أدب الناشئة
/ ثقافة الأطفال أدب الناشئة
2006
Please be aware that the book you have requested cannot be checked out. If you would like to checkout this book, you can reserve another copy

We have requested the book for you!
Your request is successful and it will be processed during the Library working hours. Please check the status of your request in My Requests.

Oops! Something went wrong.
Looks like we were not able to place your request. Kindly try again later.

Book
الجراثيم العلامة
2006
Available to read in the library!
Request Book From Autostore
and Choose the Collection Method
Publisher
Scholastic,[الطابع غير محدد]
ISBN
9780439857284
Item info:
2
items available
2
items total in all locations
| Call Number | Copies | Material | Location |
|---|---|---|---|
| QR 57 .C65125 2006 | 1 | CHILDBOOK | CHILDREN |
| 1 | CHILDBOOK | AUTOSTORE |
This website uses cookies to ensure you get the best experience on our website.